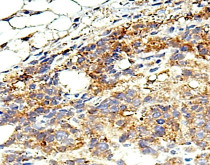

ARG66984
anti-ST3GAL1 antibody
anti-ST3GAL1 antibody for IHC-Frozen sections,IHC-Formalin-fixed paraffin-embedded sections,Western blot and Human,Mouse
Overview
| Product Description | Rabbit Polyclonal antibody recognizes ST3GAL1 |
|---|---|
| Tested Reactivity | Hu, Ms |
| Predict Reactivity | Rat |
| Tested Application | IHC-Fr, IHC-P, WB |
| Host | Rabbit |
| Clonality | Polyclonal |
| Isotype | IgG |
| Target Name | ST3GAL1 |
| Antigen Species | Human |
| Immunogen | Synthetic peptide around the middle region of Human ST3GAL1. |
| Conjugation | Un-conjugated |
| Protein Full Name | ST3 beta-galactoside alpha-2,3-sialyltransferase 1 |
| Alternate Names | ST3O; SIAT4A; SIATFL; ST3GalA; ST3GalIA; Gal-NAc6S; ST3GalA.1; ST3GalIA,1; CMP-N-Acetylneuraminate-Beta-Galactosamide-Alpha-2,3-Sialyltransferase 1; Sialyltransferase 4A (Beta-Galactosidase Alpha-2,3-Sialytransferase); Gal-Beta-1,3-GalNAc-Alpha-2,3-Sialyltransferase; Beta-Galactoside Alpha-2,3-Sialyltransferase 1; Monosialoganglioside Sialyltransferase; Alpha 2,3-ST 1 |
Application Instructions
| Application Suggestion |
|
||||||||
|---|---|---|---|---|---|---|---|---|---|
| Application Note | * The dilutions indicate recommended starting dilutions and the optimal dilutions or concentrations should be determined by the scientist. | ||||||||
| Observed Size | 45-50 kDa |
Properties
| Form | Liquid |
|---|---|
| Purification | Affinity purified. |
| Buffer | 100 mM Tris Glycine (pH 7.0), 0.025% ProClin 300 and 20% Glycerol. |
| Preservative | 0.025% ProClin 300 |
| Stabilizer | 20% Glycerol |
| Storage Instruction | For continuous use, store undiluted antibody at 2-8°C for up to a week. For long-term storage, aliquot and store at -20°C. Storage in frost free freezers is not recommended. Avoid repeated freeze/thaw cycles. Suggest spin the vial prior to opening. The antibody solution should be gently mixed before use. |
| Note | For laboratory research only, not for drug, diagnostic or other use. |
Bioinformation
| Database Links |
Swiss-port # P54751 Mouse CMP-N-acetylneuraminate-beta-galactosamide-alpha-2,3-sialyltransferase 1 Swiss-port # Q11201 Human CMP-N-acetylneuraminate-beta-galactosamide-alpha-2,3-sialyltransferase 1 |
|---|---|
| Gene Symbol | ST3GAL1 |
| Gene Full Name | ST3 beta-galactoside alpha-2,3-sialyltransferase 1 |
| Background | The protein encoded by this gene is a type II membrane protein that catalyzes the transfer of sialic acid from CMP-sialic acid to galactose-containing substrates. The encoded protein is normally found in the Golgi but can be proteolytically processed to a soluble form. Correct glycosylation of the encoded protein may be critical to its sialyltransferase activity. This protein, which is a member of glycosyltransferase family 29, can use the same acceptor substrates as does sialyltransferase 4B. Two transcript variants encoding the same protein have been found for this gene. Other transcript variants may exist, but have not been fully characterized yet. [provided by RefSeq, Jul 2008] |
| Function | A beta-galactoside alpha2-3 sialyltransferase involved in terminal sialylation of glycoproteins and glycolipids (PubMed:31784620, PubMed:8027041). Catalyzes the transfer of sialic acid (N-acetyl-neuraminic acid; Neu5Ac) from the nucleotide sugar donor CMP-Neu5Ac onto acceptor Galbeta-(1->3)-GalNAc-terminated glycoconjugates through an alpha2-3 linkage (PubMed:31784620, PubMed:8027041). Adds sialic acid to the core 1 O-glycan, Galbeta-(1->3)-GalNAc-O-Ser/Thr, which is a major structure of mucin-type O-glycans. As part of a homeostatic mechanism that regulates CD8-positive T cell numbers, sialylates core 1 O-glycans of T cell glycoproteins, SPN/CD43 and PTPRC/CD45. Prevents premature apoptosis of thymic CD8-positive T cells prior to peripheral emigration, whereas in the secondary lymphoid organs controls the survival of CD8-positive memory T cells generated following a successful immune response (By similarity). Transfers sialic acid to asialofetuin, presumably onto Galbeta-(1->3)-GalNAc-O-Ser (By similarity). Sialylates GM1a, GA1 and GD1b gangliosides to form GD1a, GM1b and GT1b, respectively (PubMed:8027041) (By similarity). [UniProt] |
| Cellular Localization | Golgi apparatus; Membrane; Secreted |
| Calculated MW | 39 kDa |
| PTM | Disulfide bond; Glycoprotein |
Images (5) Click the Picture to Zoom In
-
ARG66984 anti-ST3GAL1 antibody IHC-P image
Immunohistochemistry: Paraffin-embedded Human liver carcinoma tissue section stained with ARG66984 anti-ST3GAL1 antibody at 1:100 dilution.
-
ARG66984 anti-ST3GAL1 antibody IHC-Fr image
Immunohistochemistry: Frozen Human cancer tissue stained with ARG66984 anti-ST3GAL1 antibody at 1:200 dilution.
-
ARG66984 anti-ST3GAL1 antibody WB image
Western blot: HepG2, U2OS and PC-3 cells stained with ARG66984 anti-ST3GAL1 antibody at 1:1000 dilution.
-
ARG66984 anti-ST3GAL1 antibody IHC-P image
Immunohistochemistry: Paraffin-embedded human cancer tissue section stained with ARG66984 anti-ST3GAL1 antibody at 1:100 dilution.
-
ARG66984 anti-ST3GAL1 antibody IHC-P image
Immunohistochemistry: Paraffin-embedded Human liver carcinoma tissue section stained with ARG66984 anti-ST3GAL1 antibody at 1:100 dilution.